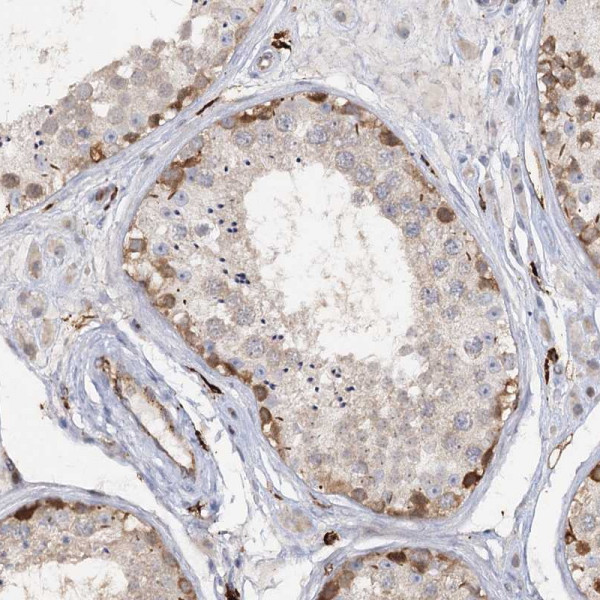
Anti-PIWIL4

Cookie preferences
This website uses cookies, which are necessary for the technical operation of the website and are always set. Other cookies, which increase the comfort when using this website, are used for direct advertising or to facilitate interaction with other websites and social networks, are only set with your consent.
Configuration
Technically required
These cookies are necessary for the basic functions of the shop.
"Allow all cookies" cookie
"Decline all cookies" cookie
CSRF token
Cookie preferences
Currency change
Customer-specific caching
FACT-Finder tracking
Individual prices
Selected shop
Session
Comfort functions
These cookies are used to make the shopping experience even more appealing, for example for the recognition of the visitor.
Note
Show the facebook fanpage in the right blod sidebar
Statistics & Tracking
Affiliate program
Conversion and usertracking via Google Tag Manager
Track device being used
| Item number | Size | Datasheet | Manual | SDS | Delivery time | Quantity | Price |
|---|---|---|---|---|---|---|---|
| ATA-HPA036588.25 | 25 µl | - |
7 - 10 business days* |
330.00€
|
|||
| ATA-HPA036588.100 | 100 µl | - |
7 - 10 business days* |
463.00€
|
If you have any questions, please use our Contact Form.
You can also order by e-mail: info@biomol.com
Larger quantity required? Request bulk
You can also order by e-mail: info@biomol.com
Larger quantity required? Request bulk
Protein function: Plays a central role during spermatogenesis by repressing transposable elements... more
Product information "Anti-PIWIL4"
Protein function: Plays a central role during spermatogenesis by repressing transposable elements and preventing their mobilization, which is essential for the germline integrity. Acts via the piRNA metabolic process, which mediates the repression of transposable elements during meiosis by forming complexes composed of piRNAs and Piwi proteins and governs the methylation and subsequent repression of transposons. Directly binds piRNAs, a class of 24 to 30 nucleotide RNAs that are generated by a Dicer-independent mechanism and are primarily derived from transposons and other repeated sequence elements. Associates with secondary piRNAs antisense and PIWIL2/MILI is required for such association. The piRNA process acts upstream of known mediators of DNA methylation. Does not show endonuclease activity. Plays a key role in the piRNA amplification loop, also named ping-pong amplification cycle, by acting as a 'slicer-incompetent' component that loads cleaved piRNAs from the 'slicer-competent' component PIWIL2 and target them on genomic transposon loci in the nucleus. May be involved in the chromatin-modifying pathway by inducing 'Lys-9' methylation of histone H3 at some loci (PubMed:17544373). In addition to its role in germline, PIWIL4 also plays a role in the regulation of somatic cells activities. Plays a role in pancreatic beta cell function and insulin secretion. Involved in maintaining cell morphology and functional integrity of retinal epithelial through Akt/GSK3alpha/beta signaling pathway (PubMed:28025795). When overexpressed, acts as an oncogene by inhibition of apoptosis and promotion of cells proliferation in tumors (PubMed:22483988). [The UniProt Consortium] Buffer: 40% glycerol and PBS (pH 7.2). 0.02% sodium azide is added as preservative. Highest antigen sequence identity to mouse: 74% and to rat: 73%
| Keywords: | Anti-HIWI2, Anti-PIWIL4, Anti-Piwi-like protein 4 |
| Supplier: | Atlas Antibodies |
| Supplier-Nr: | HPA036588 |
Properties
| Application: | IHC |
| Antibody Type: | Polyclonal |
| Conjugate: | No |
| Host: | Rabbit |
| Species reactivity: | human |
| Immunogen: | Recombinant Protein Epitope Signature Tag (PrEST) antigen sequence: AQSLNTWLIL CSDRTEYVAE SFLNCLRRVA GSMGFNVDYP KIIKVQENPA AFVRAIQQYV DPDVQLVMCI LPSNQKTYYD SI (ATA-APrEST80554) |
Database Information
| KEGG ID : | K02156 | Matching products |
| UniProt ID : | Q7Z3Z4 | Matching products |
| Gene ID : | GeneID 143689 | Matching products |
| Protein Atlas Nr. : | ENSG00000134627 |
Handling & Safety
| Storage: | -20°C |
| Shipping: | +20°C (International: +20°C) |
Caution
Our products are for laboratory research use only: Not for administration to humans!
Our products are for laboratory research use only: Not for administration to humans!
Information about the product reference will follow.
more
You will get a certificate here
Viewed

